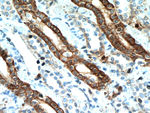
IL17RB Antibody in Immunohistochemistry (Paraffin) (IHC (P))

Search
Proteintech
IL17RB Polyclonal Antibody
{{$productOrderCtrl.translations['antibody.pdp.commerceCard.promotion.promotions']}}
{{$productOrderCtrl.translations['antibody.pdp.commerceCard.promotion.viewpromo']}}
{{$productOrderCtrl.translations['antibody.pdp.commerceCard.promotion.promocode']}}: {{promo.promoCode}} {{promo.promoTitle}} {{promo.promoDescription}}. {{$productOrderCtrl.translations['antibody.pdp.commerceCard.promotion.learnmore']}}
产品信息
20673-1-AP
种属反应
已发表种属
宿主/亚型
分类
类型
抗原
偶联物
形式
浓度
规格
纯化类型
保存液
内含物
保存条件
运输条件
产品详细信息
The antibody is specific to IL17RB.
靶标信息
Recently, a number of cytokines belonging to the interleukin (IL)-17 family have been identified. These are termed as IL-17B, IL-17C (1) and IL-17E. IL-17 is a potent proinflammatory cytokine that plays roles in a number of diseases including rheumatoid arthritis, multiple sclerosis, and promotion of tumor growth. IL-17B, C, and E like IL-17 are able to induce proinflammatory responses. However, they do not bind to the IL-17 receptor suggesting that additional IL-17R related receptor might exist. Receptor for IL-17B and IL-17E has been independently isolated and has been designated as EV127 (in mouse) and IL-17Rh1 (in human), respectively. IL-17E induces activation of NF-kB pathway and like IL-17 also induces production of IL-8. IL-17Rh1 mRNA is highly expressed in Kidney and liver and at moderate level in small intestine, colon, and brain.
仅用于科研。不用于诊断过程。未经明确授权不得转售。
生物信息学
蛋白别名: cytokine receptor CRL4; Cytokine receptor-like 4; EVI27A; IL-17 receptor B; IL-17 receptor homolog 1; IL-17B; IL-17B receptor; IL-17RB; IL-17Rh1; IL-20; interleukin 17 receptor homolog 1; Interleukin-17 receptor B; Interleukin-17B receptor; MGC138900; MGC138901; MGC5245; ZCYTO7
基因别名: CRL4; EVI27; IL17BR; IL17RB; IL17RH1; UNQ2501/PRO19612
UniProt ID: (Human) Q9NRM6
Entrez Gene ID: (Human) 55540